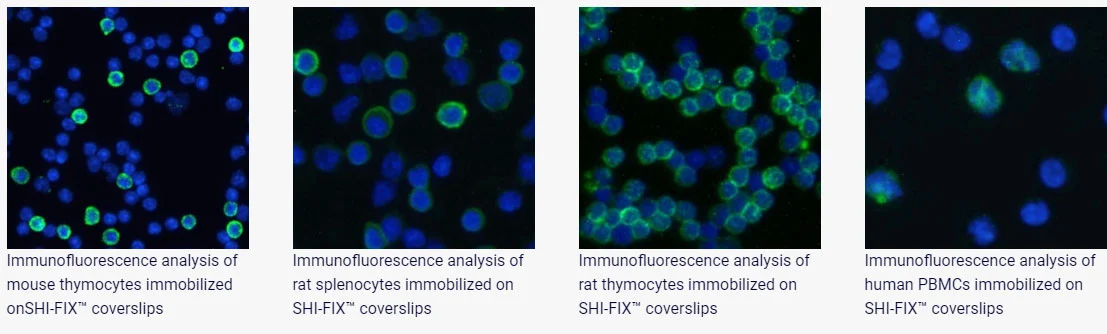

Shi-fix ™ coverslips
Do you wish immunofluorescence of suspension cells was as easy as with adherent cells? Now it is! Shi-fix™ (manufactured by Shikhar Biotech) cover-slips allow suspension cells to be layered on them or directly grown as a monolayer. Easy, hassle-free protocol and no spin columns needed for fixing suspension cells to slides. Just add your cells to the coverslips, wait for 30 mins, wash unbound cells with PBS and proceed to immunostaining (or continue the culture to obtain desired cell densities).
These cover-slips can also be used for staining suspension cells for microscopy, or for fixing suspension cells for confocal microscopy. What’s more, you can also stimulate the cells while they are attached on the cover-slip, should you need to do so. You can work on non-adherent cells as if they were adherent!
For the differences between Shi-fix and Shi-fix Plus please see our technical support page here.
Please find the datasheet for all Shi-fix products here.
Suspension cell immunofluorescence with Shi-fix™ coverslips

| Product code | Pack size | Dimensions | Product Page |
| SB-Shifix25 | Pack of 25 | ø 12mm x 0.17mm (#1.5) | £100 |
| SB-Shifix50 | Pack of 50 | ø 12mm x 0.17mm (#1.5) | £190 |
| SB-Shifix50PLUS | Pack of 50 | ø 15mm x 0.17mm (#1.5) | £260 |
| SB-PLL-100 | Pack of 100 | ø 15 mm × 0.17mm (#1.5) | £130 |
We distribute to all European countries, USA and Canada. Please contact us for pricing and lead time here.
Shi-fix coverslips have been successfully used in the following papers:
Emily R Hildebrandt et al. (2024) Targeted genetic and small molecule disruption of N-Ras CaaX cleavage alters its localization and oncogenic potential. Bioorg Chem. 2024 Jun:147:107316. PMID: 38583246.
Ji Eun Shin et al. (2023) Targeting FLT3-TAZ signaling to suppress drug resistance in blast phase chronic myeloid leukemia. Mol Cancer. 2023 Nov 6;22(1):177. PMID: 37932786.
Lizhong Yao et al. (2023) Cancer-associated fibroblasts impair the cytotoxic function of NK cells in gastric cancer by inducing ferroptosis via iron regulation. Redox Biol. 2023 Nov:67:102923. PMID: 37832398.
Rinako Nakagawa et al. (2023) Epi-microRNA mediated metabolic reprogramming ensures affinity maturation. bioRxiv. 2023 Oct 31:2023.07.31.551250. PMID: 37609190.
Ana Portelinha et al. (2023) Synthetic lethality of drug-induced polyploidy and BCL-2 inhibition in lymphoma. Nat Commun. 2023 Mar 18;14(1):1522. PMID: 36934096.
Xiaoyong Chen et al. (2022) Inhibition of NETosis by a Nuclear-Penetrating Anti-DNA Autoantibody. Immunohorizons. 2022 Jun 13;6(6):356-365. PMID: 35697479.
Hiroya Shiba et al. (2022) Carboxy-terminal dendrimers with phenylalanine for a pH-sensitive delivery system into immune cells including T cells. J Mater Chem B. 2022 Apr 6;10(14):2463-2470. PMID: 34935852.
Jeffrey R Whiteaker et al. (2021) Targeted Mass Spectrometry Enables Quantification of Novel Pharmacodynamic Biomarkers of ATM Kinase Inhibition. Cancers (Basel). 2021 Jul 30;13(15):3843. PMID: 34359745.
Rima Kandil et al. (2019) Coming in and Finding Out: Blending Receptor-Targeted Delivery and Efficient Endosomal Escape in a Novel Bio-Responsive siRNA Delivery System for Gene Knockdown in Pulmonary T Cells. Adv Ther (Weinh). 2019 Jul;2(7):1900047. PMID: 31372493.
Servando Hernandez Vargas et al. (2019) Specific Targeting of Somatostatin Receptor Subtype-2 for Fluorescence-Guided Surgery. Clin Cancer Res. 2019 Jul 15;25(14):4332-4342. PMID: 31015345.